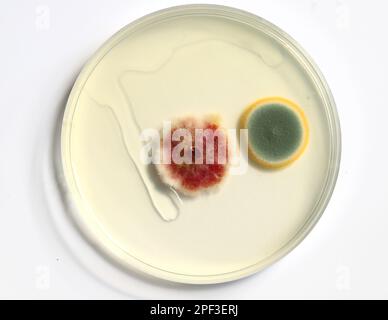
Piastre Di Petri Con Agar - 10 Pezzi Preversati, Per Colture Cellulari E Laboratorio - Foto 11

Piastre Di Petri Con Agar - 10 Pezzi Preversati, Per Colture Cellulari E Laboratorio
Disponibile
Disponibile
€ 8
AGGIUNGI AL CARRELLO
Consegna
- Corriere espressoda martedì 24 febbraioGRATIS
Venduto e spedito da ePRICE

Altri 2 venditori a partire da € 8
- Informazioni legali
- Ne hai uno da vendere?
- 441614
- 58925641829
Pensati per Te
Prodotti simili
Descrizione
Queste piastre di Petri sono essenziali per esperimenti scientifici! Il set include 10 piastre preversate con agar nutriente, pronte per colture cellulari, funghi o batteri. Sono della dimensione perfetta per progetti scolastici, laboratori o hobbisti. Realizzate in materiale durevole, sono portatili e facili da usare. Ideali per isolare colture pure o per conservazione. Un must per chi ama la biologia e la ricerca!Caratteristiche e scheda tecnica
Caratteristiche principali
- EAN8199365690680
Recensioni
2026-02-21 | i0tmagl